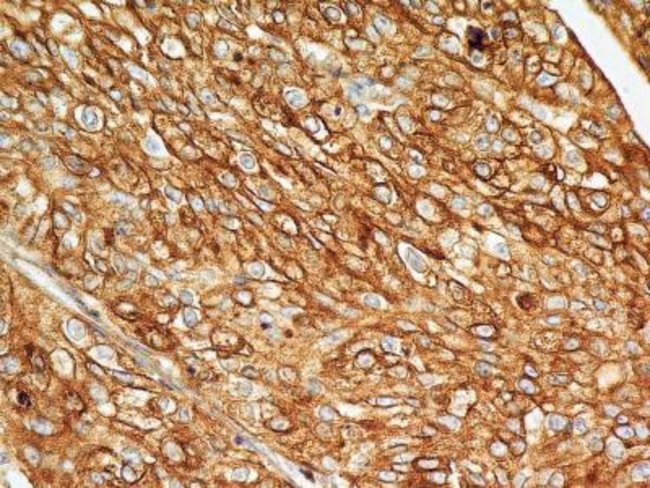

Anti-Bst2, Clone: 4f6, Mouse Monoclonal Antibody, Each
$ 278.78
|
|
Details:
BST2 Monoclonal specifically detects BST2 in Human samples. It is validated for Western Blot, Flow Cytometry, Immunohistochemistry, Immunohistochemistry-Paraffin, Flow (Cell Surface), CyTOF-ready.
Additional Information
| SKU | 10153588 |
|---|---|
| UOM | Each |
| UNSPSC | 60104000 |
| Manufacturer Part Number | NBP229622SS |
